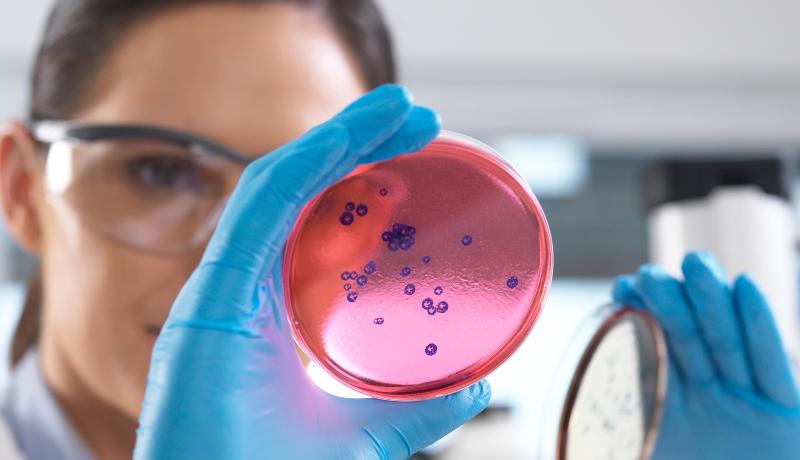

Wil je bijdragen aan technologische innovatie en de maatschappij van morgen vormgeven? Laat je omscholen naar de techniek! Door de groeiende vraag naar technisch personeel is er meer dan ooit behoefte aan gedreven professionals. Met onze praktijkgerichte opleidingen, cursussen en trainingen kun je je verdiepen in de techniek of een carrièreswitch maken.
Omscholingstraject Be an Engineer
Ben je toe aan een carrièreswitch? Lijkt het vakgebied engineering vakgebied je interessant, maar mis je de juiste vooropleiding of ervaring? Dan is Be an Engineer iets voor jou! Via dit traject werk je toe naar een betaalde baan in de techniek en volg je tegelijkertijd een deeltijdopleiding naar keuze.
Op de website van Be an Engineer lees je er meer over. Hier zie je welke deeltijdopleidingen je bij ons kunt volgen als je meedoet.
Omscholingstraject Be an Engineer
Overweeg je een overstap naar de techniek?
Bezoek de informatieavond voor professionals en ontdek welke deeltijdopleidingen, cursussen en trainingen bij jou passen. Kijk voor meer informatie en aanmelden op: hanze.nl/informatieavond.

The dog trainer who became an R&D engineer
Lees hier het verhaal van Erik
Veelgestelde vragen
Feedback component
Hoe tevreden ben jij met de informatie op deze pagina?
.jpg?_jwt=eyJhbGciOiJIUzUxMiIsInR5cCI6IkpXVCJ9.eyJ1cmwiOiJodHRwczovL3d3dy5oYW56ZS5ubC9iaW5hcmllcy9jb250ZW50L2dhbGxlcnkvaGFuemUvYWxnZW1lZW4tZ2VicnVpay0tLWNhbXB1cy9ib3V3a3VuZGUtcm9uZGxlaWRpbmdfejYzMTYxMi0xLmpwZz90cz0xNzY1MjkzOTM1MTMzIiwid2lkdGgiOjgwMCwiaGVpZ2h0Ijo0NjAsImZvY3VzUG9pbnRYIjowLjAsImZvY3VzUG9pbnRZIjowLjAsImlzcyI6ImYyMWVjZjc4Yzg0MzRkNWRiNDFmNWQ4YTNhZDBmNmRhIiwiYWN0aW9uIjoidHJhbnNmb3JtIn0.h5OiOqA9hypXN5BqW8k6Jwzf-JEdVKFGNjYq2FAGyBcbTxL9Pfn7KhfqWmfNDeo52QkFF4xW4PfH5CBshS3C0g)







.jpg?_jwt=eyJhbGciOiJIUzUxMiIsInR5cCI6IkpXVCJ9.eyJ1cmwiOiJodHRwczovL3d3dy5oYW56ZS5ubC9iaW5hcmllcy9jb250ZW50L2dhbGxlcnkvaGFuemUvYWZkZWxpbmdlbi9mb3RvLTItMS5qcGc_dHM9MTc3NjMzMjIxNzkwNSIsIndpZHRoIjo4MDAsImhlaWdodCI6NDYwLCJmb2N1c1BvaW50WCI6MC4wLCJmb2N1c1BvaW50WSI6MC4wLCJpc3MiOiJmMjFlY2Y3OGM4NDM0ZDVkYjQxZjVkOGEzYWQwZjZkYSIsImFjdGlvbiI6InRyYW5zZm9ybSJ9.-a153NagYWCbulV8ucSu0JdazEAaqiO8sDxndGzDzr7mCg5f9YmjZc8_cLCpIr7xy1gdFOl8j_xYYqZyKftvDw)
.png?_jwt=eyJhbGciOiJIUzUxMiIsInR5cCI6IkpXVCJ9.eyJ1cmwiOiJodHRwczovL3d3dy5oYW56ZS5ubC9iaW5hcmllcy9jb250ZW50L2dhbGxlcnkvaGFuemUvb3BsZWlkaW5nZW4vdm9vci1wcm9mZXNzaW9uYWxzLS1vcmdhbmlzYXRpZXMvYWZiZWVsZGluZ2VuLW9wbGVpZGluZ3NwYWdpbmFzL2hiby1pY3QtZGVlbHRpamQucG5nP3RzPTE3MzE5MjkwNzYxNzUiLCJ3aWR0aCI6ODAwLCJoZWlnaHQiOjQ2MCwiZm9jdXNQb2ludFgiOjAuNDUsImZvY3VzUG9pbnRZIjowLjQ5LCJpc3MiOiJmMjFlY2Y3OGM4NDM0ZDVkYjQxZjVkOGEzYWQwZjZkYSIsImFjdGlvbiI6InRyYW5zZm9ybSJ9.i0T1TxmmB0Uw_mSxRhTwf40q0HtNUP7R5sCYbYbP-np5FBb2LfN5DpMI7vzKdLqefMKUzjIFLlyPwTbXytv5xw)







.png?_jwt=eyJhbGciOiJIUzUxMiIsInR5cCI6IkpXVCJ9.eyJ1cmwiOiJodHRwczovL3d3dy5oYW56ZS5ubC9iaW5hcmllcy9jb250ZW50L2dhbGxlcnkvaGFuemUvb3BsZWlkaW5nZW4vdm9vci1wcm9mZXNzaW9uYWxzLS1vcmdhbmlzYXRpZXMvYWZiZWVsZGluZ2VuLW9wbGVpZGluZ3NwYWdpbmFzL29wZnJpc2N1cnN1cy1uYXR1dXJrdW5kZS0yLnBuZz90cz0xNzM4NzUyMjA4MjUwIiwid2lkdGgiOjgwMCwiaGVpZ2h0Ijo0NjAsImZvY3VzUG9pbnRYIjotMC4xMSwiZm9jdXNQb2ludFkiOjAuNDIsImlzcyI6ImYyMWVjZjc4Yzg0MzRkNWRiNDFmNWQ4YTNhZDBmNmRhIiwiYWN0aW9uIjoidHJhbnNmb3JtIn0.MsBzi9sQXalM2ILUwKZP9qSSHT11rlxAXSGNciitNeXKiVLlgZlj8NH2E9S3uncCm-t1DgRazmekdSSR-8Vkpw)